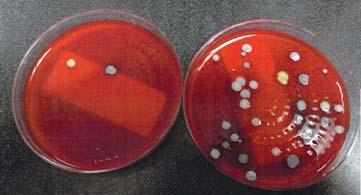

6 minute read
Warming Devices May Be Source of Airborne Microbial Contamination, but Fix Is Possible
By MICHAEL VLESSIDES
New research has identifi ed an unexpected source of airborne microbial contamination in the OR as the Neptune (Stryker) surgical suction system or the Bair Hugger (3M) forcedair warming device, both of which discharge exhaust into the OR environment.
Th ese sources of contamination, the researchers noted, may be mitigated by changing the devices’ HEPA fi lters more regularly, or adding a high-effi ciency fi lter at the end of the Bair Hugger’s exhaust hose.
“Th e CDC recognizes operating room air as a potential source of surgical site infections, and has published several strategies to limit infections resulting from airborne microbes,” said Justin Ward, MD, the chief resident, Department of Anesthesiology, at Stanford University, in California. “Both the Neptune surgical suction system and the Bair Hugger forced-air warmer have been staples in operating rooms for many years, and both emit HEPAfi ltered air into the OR environment from their exhaust ports.
“We know that HEPA-fi ltered air should capture at least 99.97% of particles greater than 0.3 microns in size. But it’s also true that time and particulate loading can degrade the effi ciency of these fi lters. So we wanted to see if these devices might be contributing airborne microbes to operating room air,” Dr. Ward said.
To do so, Dr. Ward and his colleagues collected 200-L air samples from each device and from OR air inlets in 12 randomly selected ORs, using an industry-standard portable microbial air sampler.
Sample plates were incubated at 30° C to 35° C for three days, followed by four days at 20° C to 25° C, and then interpreted for colony counts. Th e researchers identifi ed colony organisms using DNA sequencing technology.
Th e study found that the total colony counts (colony-forming units per m3) from the exhaust of the Neptune device were not signifi cantly diff erent from those obtained from room air. In contrast, colony counts obtained from the Bair Hugger’s output hose were signifi cantly higher (P=0.0005) than in room air.
“Th e Bair Hugger emitted over twice the number of colony-forming units as did the Neptune, and four times as many colony-forming units as room air,” Dr. Ward said (Figure).
Th e study also found extreme variation in colony counts between the two devices. Th is fi nding, the investigators said, indicates that some individual Neptune and Bair Hugger units may be signifi cant sources of contamination.
“Th e samples from the Neptune and the Bair Hugger were notably more variable than those from room air,” Dr. Ward said. “Th is is important because if all the HEPA fi lters are performing at the same effi ciency, we would expect no diff erence in variability. But that isn’t what we found.”
In total, four organisms identifi ed as human pathogens were common to all sources and assumed to be present in room air. Th ree human pathogens were unique to only the Neptune or Bair Hugger, and not isolated from the OR air inlet.
Figure. Colony counts from room air (left) and the Neptune system’s exhaust port, sampled from one OR in the study.
Manufacturer Disputes Findings
A spokesman for 3M, Sean Lynch, disagreed with the fi ndings. “For 30 years, the 3M Bair Hugger system has been a safe and eff ective method of keeping patients warm before, during and after surgery,” he said. “Th ere is no legitimate scientifi c support for claims that the Bair Hugger system can cause infection. Th e U.S. FDA, independent institutions including Duke University’s Infection Control Outreach Network (DICON), and federal and state courts that have examined claims of whether the Bair Hugger can cause infection have consistently rejected them.
“Scientifi c research supports the conclusion that the Bair Hugger system helps patients by maintaining normothermia, which is associated with reducing the risk of infection, shortening recovery time and improving patient comfort,” Mr. Lynch said.
Th e good news, however, is that the investigators proposed a fi x: Change the HEPA fi lters in both devices based on usage instead of time.
“Th is could look something like a meter on the machine that shows hours of use,” Dr. Ward said. “Th en those machines being used more often would be identifi ed before their fi lters lost effi ciency.” Institutions should also consider placing a high-effi ciency fi lter at the end of the Bair Hugger’s exhaust hose, he said.
“Since the Bair Hugger’s HEPA fi lter is located at the air intake on the bottom of the machine, that leaves the remainder of the machine and the hose open to the OR air and able to collect particulate matter in the corrugated tubing. Th is is supported by swab studies of that tubing showing several species of Staphylococcus,” Dr. Ward explained.
Th e researchers also suggested that the Neptune system’s exhaust could be routed outside the hospital, via an existing suction system.
“Th e infrastructure is there, and it would obviate any concern for OR contamination from these devices,” Dr. Ward added. Stryker was asked to comment but did not reply to our request. ■








Introducing ATEM Mini Pro
The compact television studio that lets you create presentation videos and live streams!
Blackmagic Design is a leader in video for the medical industry, and now you can create your own streaming videos with ATEM Mini. Simply connect up to 4 HDMI cameras, computers or even technical equipment. Then push the buttons on the panel to switch video sources just like a professional broadcaster! You can even add titles,picture in picture overlays and mix audio! Then live stream to Zoom, Skype or YouTube!
Create Training and Educational Videos
ATEM Mini’s includes everything you need. All the buttons are positioned on the front panel so it’s very easy to learn. There are 4 HDMI video inputs for connecting cameras and computers, plus a USB output that looks like a webcam so you can connect to Zoom or Skype. ATEM Software Control for Mac and PC is also included, which allows access to more advanced “broadcast” features!
Use Professional Video Effects
ATEM Mini is really a professional broadcast switcher used by television stations. This means it has professional effects such as a DVE for picture in picture effects commonly used for commentating over a computer slide show. There are titles for presenter names, wipe effects for transitioning between sources and a green screen keyer for replacing backgrounds with graphics! Live Stream Training and Conferences

The ATEM Mini Pro model has a built in hardware streaming engine for live streaming via its ethernet connection. This means you can live stream to YouTube, Facebook and Twitch in much better quality and with perfectly smooth motion. You can even connect a hard disk or flash storage to the USB connection and record your stream for upload later!
Monitor all Video Inputs!
With so many cameras, computers and effects, things can get busy fast! The ATEM Mini Pro model features a “multiview” that lets you see all cameras, titles and program, plus streaming and recording status all on a single TV or monitor. There are even tally indicators to show when a camera is on air! Only ATEM Mini is a true professional television studio in a small compact design!
ATEM Mini ..........$295 ATEM Mini Pro..........$495 ATEM Mini Pro ISO..........$795